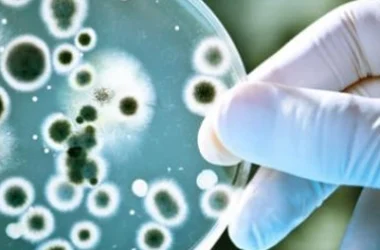

جدول المحتويات
- ما هو اسم أنثى الفيل؟
- الخصائص الشكلية لأنثى الفيل
- سلوكيات أنثى الفيل
- فترة حمل أنثى الفيل ورعاية الصغار
- المراجع
ما هو اسم أنثى الفيل؟
تُعرف أنثى الفيل في اللغة العربية باسم العَيثُومُ، وهو مصطلح مشتق من الفعل “عثم”، والذي يعني العظم المكسور أو الذي انجبر بشكل غير متساوٍ. يُستخدم هذا الاسم للإشارة إلى أنثى الفيل، كما يمكن أن يُطلق على الذكر أيضًا في بعض الأحيان. جمع كلمة عَيثُوم هو “عياثيم”.
الخصائص الشكلية لأنثى الفيل
تتميز أنثى الفيل ببعض الخصائص الشكلية التي تميزها عن الذكر، ومن أبرز هذه الخصائص:
- رأس أنثى الفيل البالغة ليس عريضًا مقارنة بالذكر، وجبهتها تشكل زاوية حادة.
- تمتلك أنثى الفيل ثديين يقعان بين أرجلها الأمامية.
- يزداد حجم أنثى الفيل بشكل ملحوظ أثناء فترة الحمل أو الرضاعة.
- أنثى الفيل البالغة عادة ما تكون أكبر حجمًا من الذكر البالغ.
- يتراوح وزن أنثى الفيل الأفريقي حوالي 3492.66 كيلوجرامًا، بينما يصل وزن الذكر إلى 6078.14 كيلوجرامًا.
- يبلغ طول أنثى الفيل الأفريقي حوالي 2.6 مترًا، بينما يصل طول الذكر إلى 4 أمتار. أما أنثى الفيل الآسيوي فتبلغ طولها حوالي 2 مترًا، والذكر حوالي 3 أمتار.
- أنياب أنثى الفيل أصغر من أنياب الذكر.
سلوكيات أنثى الفيل
تتميز أنثى الفيل بسلوكيات فريدة تساعدها على التكيف مع بيئتها وحماية صغارها. ومن أبرز هذه السلوكيات:
- تعيش إناث الفيل في قطعان كبيرة تُسمى “القطيع المتكاثر”، وتكون هذه القطعان عادة تحت قيادة الأنثى الأكبر سنًا.
- تعتمد أنثى الفيل على حاستي الشم واللمس للتواصل مع أفراد القطيع.
- تظهر أنثى الفيل سلوكًا عدوانيًا عند وجود صغارها حولها، حيث تحاول حمايتهم من أي تهديد خارجي.
- تتعاون الإناث في رعاية الصغار، مما يزيد من فرص بقائهم على قيد الحياة ويقلل من خطر تعرضهم للافتراس.
- تحب أنثى الفيل الاستحمام تحت الماء أو رش نفسها بالتراب للتخلص من الطفيليات.
- تنام أنثى الفيل حوالي 4 ساعات يوميًا، نصفها وهي واقفة والنصف الآخر وهي مستلقية.
- تتحرك أنثى الفيل بسرعة تتراوح بين 6 إلى 8 كيلومترات في الساعة.
- تكون أنثى الفيل أكثر نشاطًا في الصباح الباكر عندما يكون الطقس باردًا.
فترة حمل أنثى الفيل ورعاية الصغار
تُعتبر فترة حمل أنثى الفيل الأطول بين جميع الثدييات، حيث تتراوح بين 640 إلى 660 يومًا، أي ما يقارب عامين. عادة ما تلد أنثى الفيل صغيرًا واحدًا، ولكن في حالات نادرة قد تلد توأمًا.
خلال فترة الحمل، تسعى أنثى الفيل للتواصل مع إناث أخرى في القطيع لتوفير الدعم أثناء الولادة. تلد أنثى الفيل وهي واقفة، وتستغرق الولادة بضع دقائق فقط. بعد الولادة، تساعد الأم صغيرها على الوقوف والرضاعة، والتي تستمر لمدة عامين.
تُساعد الأمهات والإناث الأخرى في القطيع على توجيه الصغير لتمييز النباتات الصالحة للأكل وتوفير الحماية له حتى يكبر ويصبح قادرًا على الاعتماد على نفسه.
المراجع
- “تعريف و معنى عيثوم في معجم المعاني الجامع – معجم عربي عربي”، المعاني.
- “HOW CAN YOU IDENTIFY A MALE AND FEMALE ELEPHANT?”, ELEPHANT PARADE.
- Marina Somma, “How to Tell the Difference Between Male and Female Elephants”, SCIENCING.
- “Elephant Hall”, South African NATIONAL PARKS.
- “Elephants”, SEAWORLD PARKS AND ENTERTAINMENT.
- Remy Melina, “What Animal Has the Longest Pregnancy?”, LIVESCIENCE.
- “Birth and Care of Young”, SEAWORLD PARKS AND ENTERTAINMENT.